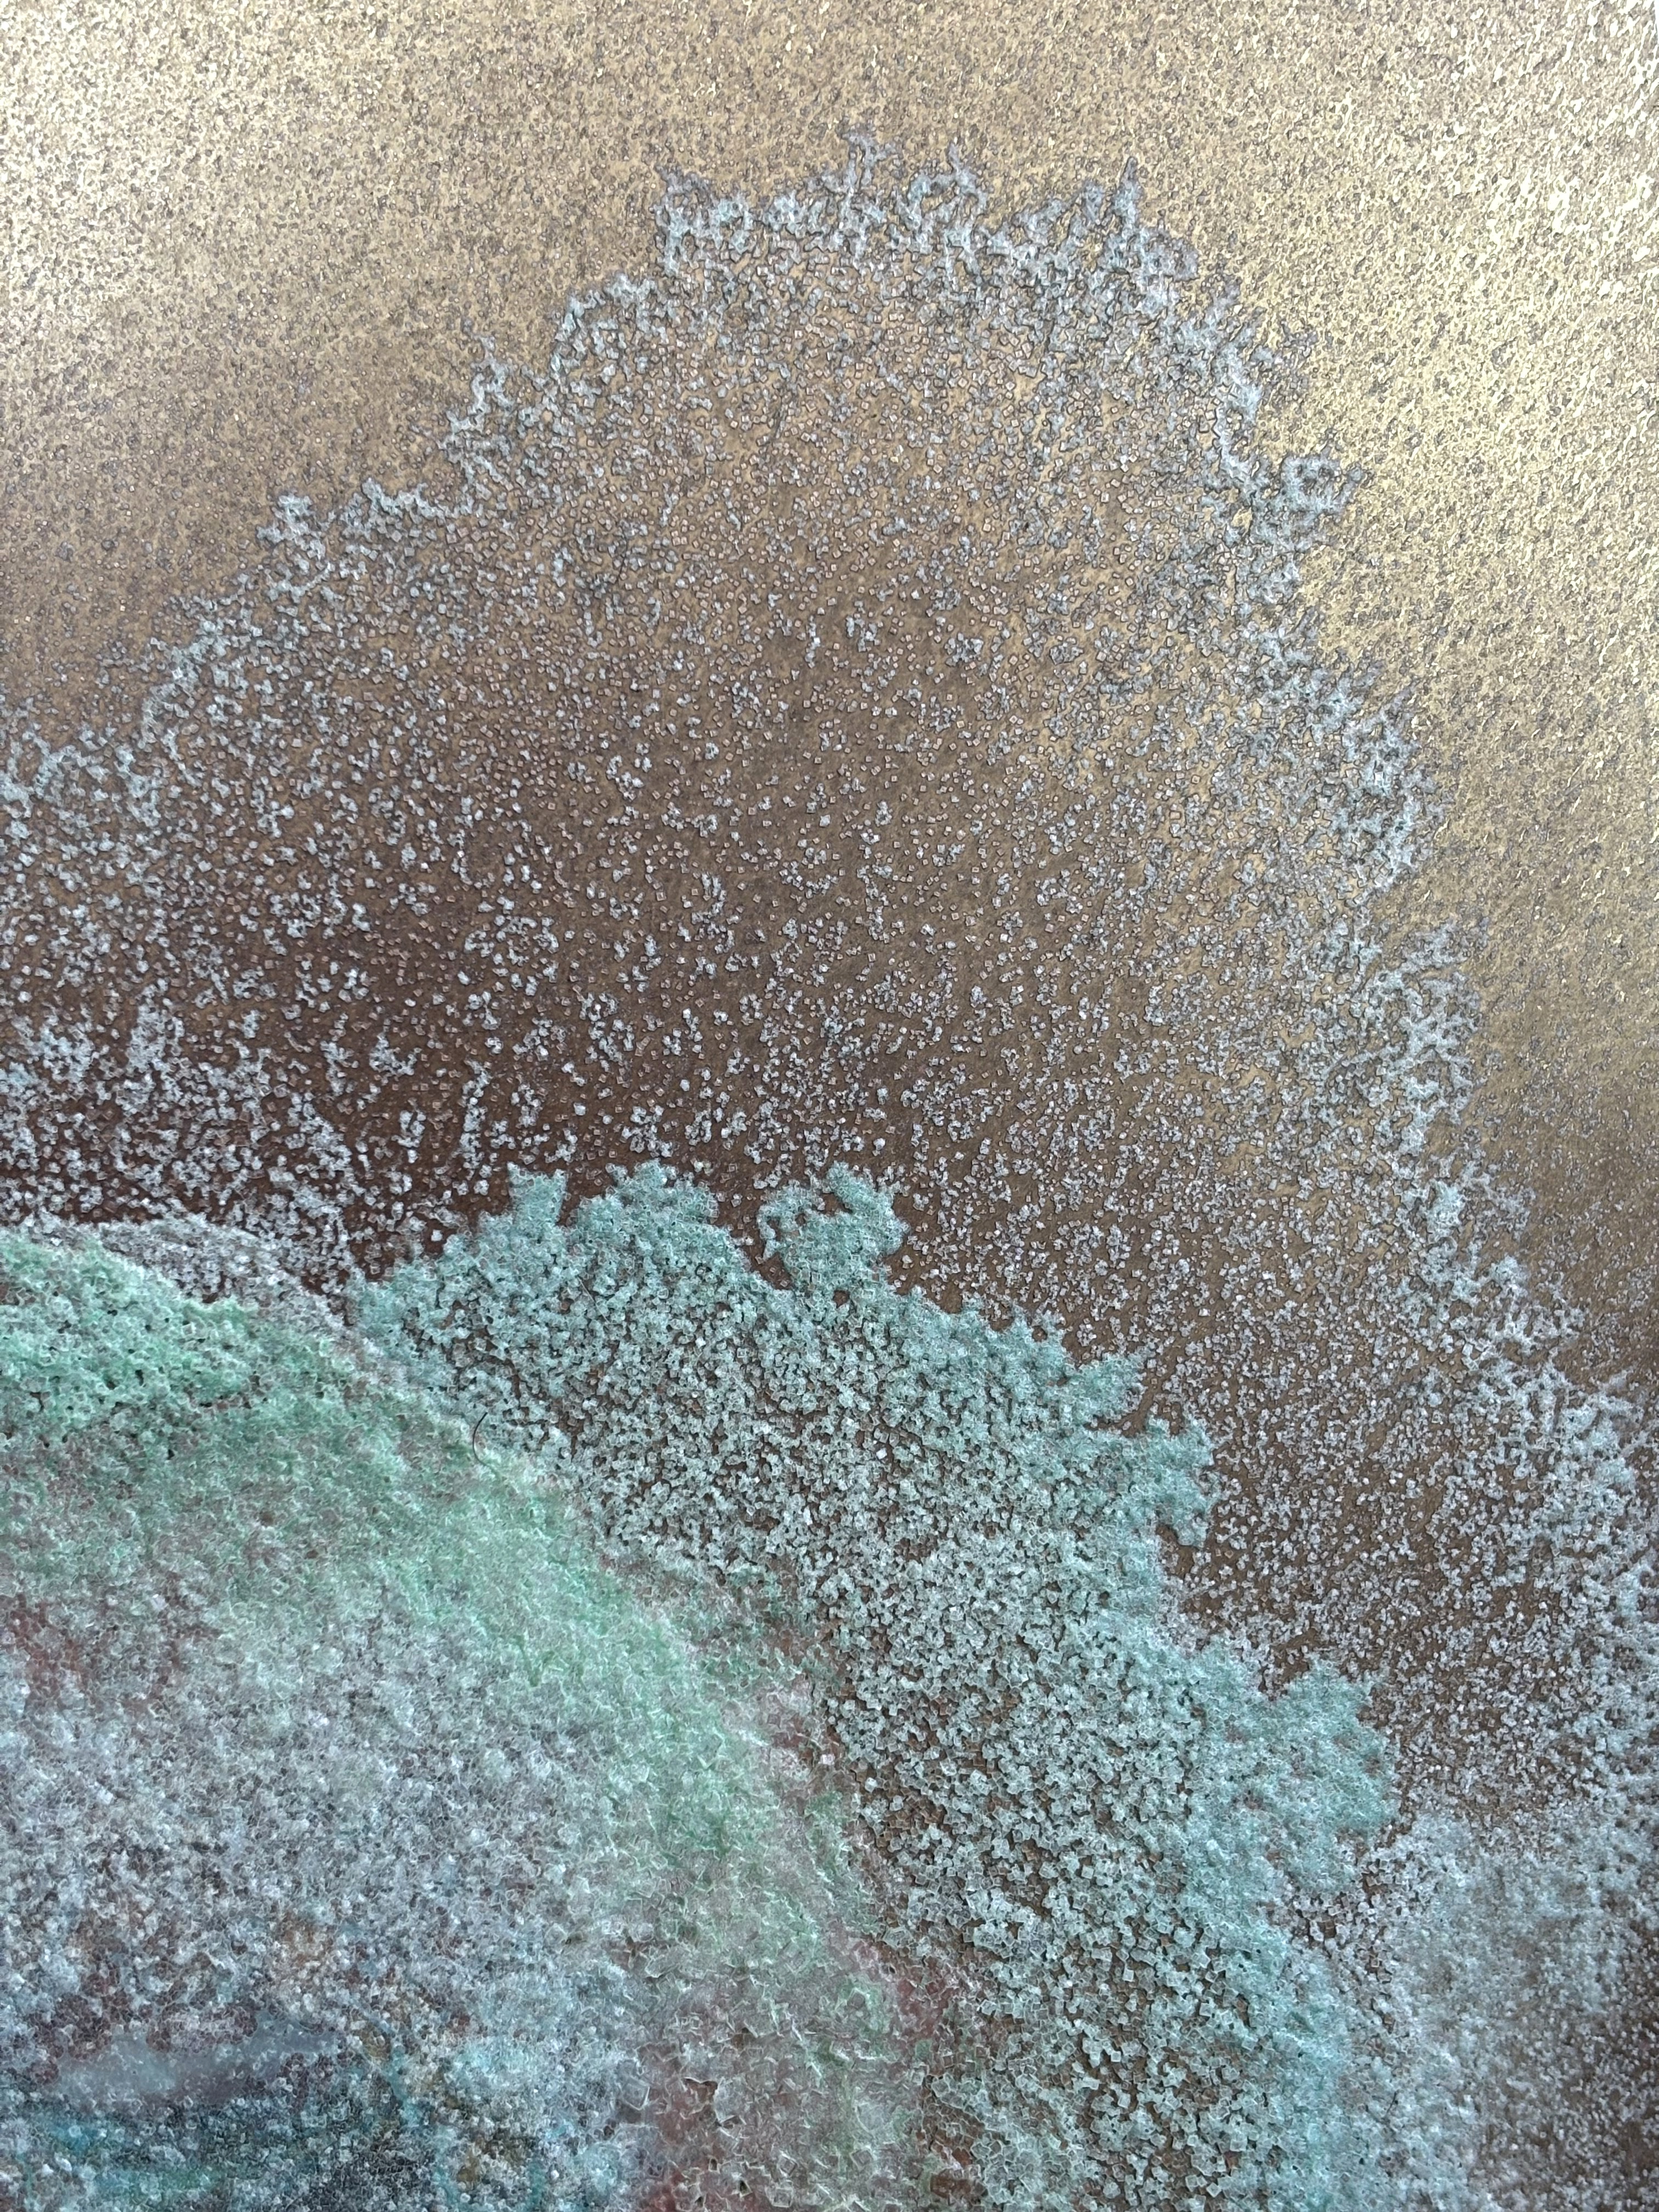

/Noche y Día
/Comisión. Santiago 2025/

/Noche y Día. Díptico/
El árido verano en Santiago se caracteriza por intensos días soleados, que se apaciguan con el frío de los Andes al caer la noche. Esta oscilación de temperatura marca un ritmo climático en la ciudad, donde la calurosa cuenca dialoga con los aún persistentes hielos de la montaña.
Como resultado de esta dicotomía nacen estas obras, realizadas durante el comienzo del verano capitalino. En la primera, las sales cristalizaron de día, bajo el sol y el aire seco, formando estructuras tensas y brillantes. En la otra, el proceso ocurrió durante la noche, cuando el frío y la quietud permitieron un crecimiento más lento y contenido de las estructuras salinas. Cada pieza cristalizó así un momento específico de este vaivén térmico en la ciudad./
Como resultado de esta dicotomía nacen estas obras, realizadas durante el comienzo del verano capitalino. En la primera, las sales cristalizaron de día, bajo el sol y el aire seco, formando estructuras tensas y brillantes. En la otra, el proceso ocurrió durante la noche, cuando el frío y la quietud permitieron un crecimiento más lento y contenido de las estructuras salinas. Cada pieza cristalizó así un momento específico de este vaivén térmico en la ciudad./

/Noche. Cristalización de sales sobre bronce-latón. 40x6cm/

/Detalle, Noche/
/Detalle, Día/

/Noche. Cristalización de sales sobre bronce-latón. 40x6cm/

